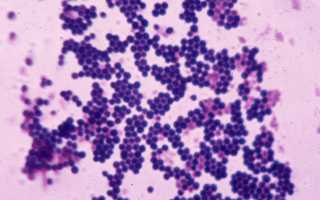

Стафилококк – это разновидность микробов, которая присутствует в организме человека с самого рождения. Обычно стафилококк не вызывает никаких проблем. Однако при нарушениях в работе иммунной системы, стафилококк может стать активным и вызвать негативные, а в некоторых случаях даже опасные последствия. Эта проблема часто возникает у беременных женщин. Если при анализе будет обнаружено активное присутствие стафилококка, необходимо немедленно начать лечение, чтобы избежать вреда для ребенка и матери.
Стафилококк в моче при беременности
Микробы стафилококка обитают и размножаются в организме человека с самого начала жизни, оставаясь незаметными и не причиняя вреда. Однако во время беременности происходят изменения в работе многих органов. Для предотвращения различных заболеваний гинекологи проводят большое количество процедур и анализов у беременных женщин, о которых они ранее не имели представления.
Во время беременности каждая женщина обязана регулярно посещать гинеколога, проводя приемы каждые 3 недели. Это необходимо для своевременного выявления любых проблем и немедленного принятия соответствующих мер.
Самые распространенные причины появления бактерий в моче:
- Ослабление иммунной системы. Резкое ослабление может привести к активации всех бактерий, которые до начала беременности не представляли бы опасности.
- Прекращение использования средств контрацепции. Многие женщины не используют средства контрацепции во время беременности, что увеличивает риск заражения различными ЗППП. В это время иммунная система ослаблена, и если раньше она могла бы справиться с некоторыми бактериями, то во время беременности это может быть проблематично.
- Заболевания почек. У каждой второй женщины возникают проблемы с почками во время беременности из-за давления, которое оказывает растущий ребенок на все органы.
- Сильные стрессы. Беременные женщины подвержены стрессу чаще других. Беспокойство о предстоящих родах, особенно если это первый опыт, стрессы из-за здоровья ребенка и другие факторы могут привести не только к активации стафилококка, но и к нарушению работы сердца.
Существует 27 разновидностей бактерий, однако лишь 4 из них способны серьезно навредить здоровью ребенка и женщины, например, золотистая.
Золотистый стафилококк при беременности в мазке
Золотистый стафилококк – это микроорганизмы, напоминающие маленькие мячи, получившие свое название из-за характерного золотистого оттенка. Присутствуют в организме каждого человека, но проявляются с особой силой во время беременности. Могут вызвать воспалительные процессы, сопровождающиеся выделением гноя при мочеиспускании, что может быть замечено женщиной в виде белых сгустков в моче.
Насколько это опасно при беременности?
Какова опасность золотистого стафилококка? Бактерии размножаются очень быстро, что приводит к образованию гнойных очагов в ранах, возникших во время родов. Они вызывают множество заболеваний, начиная от безвредной кожной сыпи и заканчивая тяжелыми заболеваниями, способными привести к летальному исходу, такими как эндокардит, менингит и сепсис.
Под воздействием золотистого стафилококка активизируются враждебные микроорганизмы, которые способны вызвать у грудных детей и многих женщин синдром токсического шока и потерю аппетита.
Золотистый стафилококк представляет собой наиболее опасный вид из 27 разновидностей, поскольку способен нанести вред не только женщине, но и развивающемуся плоду, который в первые месяцы беременности подвержен воздействию любых заболеваний и инфекций матери.
Гной, образовавшийся из-за действия бактерий, способен попасть в молоко и повлиять на его качество. Потребление такого молока не рекомендуется детям, поскольку организм ребенка может легко подвергнуться воздействию бактерий, присутствующих в молоке матери.
Возникает септический шок, что создает серьезную опасность для жизни плода. Поскольку кровяное давление матери снижается, это может привести к кислородному голоданию плода, что в свою очередь может привести к смерти ребенка.
Последствия для женщины и ребенка
Медицинские специалисты классифицируют последствия стафилококка как менее серьезные и более серьезные. Более серьезные последствия вызывают более тяжелые последствия для организма, поскольку они могут иметь летальный исход.
Результаты могут варьироваться от легких до серьезных:
- Отравление пищей. Симптомы включают рвоту, понос и повышенную температуру, которые могут длиться до двух недель.
- Сыпь на коже, поражение слизистых оболочек всего организма.
- Поражение внутренних органов, включая половую систему.
- Заражение крови, сепсис. Стафилококк может вызвать появление септических бактерий, которые приводят к заражению крови.
Что делать, чем и как лечить?
В данной ситуации абсолютно не рекомендуется пытаться лечиться самостоятельно, поэтому обращение к врачу – это обязательная процедура. В зависимости от местоположения бактерий стафилококка, специалистом назначается индивидуальная терапия для каждой пациентки. Стафилококк очень устойчив к антибиотикам, однако ни одно лечение не обходится без них.
При первых признаках насморка, кашля и повышенной температуры, необходимо немедленно обратиться в медицинское учреждение для прохождения необходимых анализов, поскольку стафилококк может повредить любой орган человека. Также специалисты рекомендуют полоскать горло раствором воды с йодом, воды с солью или соды, также эффективно применение настойки календулы с определенным содержанием спирта. При насморке рекомендуется использовать тампоны, смоченные в хлорфилипте или фурацилине, а также проводить промывание носа соляным раствором или отварами лечебных трав.
Для предотвращения попадания бактерий стафилококка в молоко и предотвращения возможного заражения ребенка, рекомендуется ежедневно промывать грудь и соски дважды в день с использованием антисептического или детского мыла, а затем вытирать их бумажными полотенцами.
Если женщина планирует беременность, то перед зачатием следует обратиться в поликлинику, чтобы сдать мазок на бактериальный посев стафилококка. При положительных результатах, следует повременить с зачатием до окончания лечения и прохождения курса профилактики.
Женщины в период беременности более подвержены различным инфекциям и заболеваниям, поэтому необходимо немедленно бороться с этими проблемами, чтобы избежать возможных отклонений у плода и предотвратить его преждевременную гибель.
Частые вопросы
Какой опасностью является наличие стафилококка при беременности?
Наличие стафилококка при беременности может увеличить риск развития инфекций как у матери, так и у плода, что может привести к серьезным осложнениям.
Какие последствия может иметь стафилококк при беременности для матери и плода?
Для матери стафилококк может вызвать инфекции мочевыводящих путей, послеродовые осложнения, а у плода — врожденные инфекции, преждевременные роды, недоношенность и другие проблемы.
Какими методами можно лечить стафилококк при беременности?
Лечение стафилококка при беременности может включать прием антибиотиков, местное лечение пораженных участков, а также меры по укреплению иммунитета и профилактике инфекций.
Полезные советы
СОВЕТ №1
Обратитесь к врачу при первых признаках инфекции, таких как кожные высыпания, лихорадка или боли в области живота, чтобы получить профессиональную консультацию и назначение лечения.
СОВЕТ №2
Следуйте рекомендациям врача относительно лечения стафилококка при беременности, включая прием антибиотиков, местное лечение пораженных участков кожи и соблюдение гигиенических мер.
СОВЕТ №3
Избегайте самолечения и использования антибиотиков без назначения врача, так как это может нанести вред как вам, так и вашему ребенку.